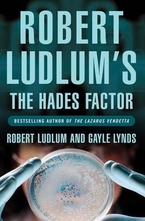
The Hades Factor

-
![The Sigma Protocol]()
печатна:
7.66 EUR |
15.00 лв.
-
![The Janson Directive]()
печатна:
7.61 EUR |
14.90 лв.
-
![The Scarlatti Inheritance]()
печатна:
7.66 EUR |
15.00 лв.
-
![The Hades Factor]()
печатна:
7.10 EUR |
13.90 лв.
-
![The Bourne Ultimatum]()
печатна:
10.17 EUR |
19.90 лв.
-
![The Bancroft Strategy]()
печатна:
7.15 EUR |
14.00 лв.
-
![The Rhinemann Exchange]()
печатна:
7.61 EUR |
14.90 лв.
-
![The Bourne Trilogy]()
печатна:
15.28 EUR |
29.90 лв.
-
![The Matlock Paper]()
печатна:
7.15 EUR |
14.00 лв.
-
![The Cassandra Compact]()
печатна:
7.10 EUR |
13.90 лв.
-
![The Tristan Betrayal]()
печатна:
7.10 EUR |
13.90 лв.
-
![The Scorpio Illusion]()
печатна:
7.61 EUR |
14.90 лв.
-
![The Icarus Agenda]()
печатна:
7.61 EUR |
14.90 лв.
-
![The Ambler Warning]()
печатна:
6.08 EUR |
11.90 лв.
-
![The Holcroft Covenant]()
печатна:
7.10 EUR |
13.90 лв.
-
![The Bourne Supremacy]()
печатна:
7.61 EUR |
14.90 лв.
-
![Road to Omaha: AND Road to Gandolfo]()
печатна:
5.06 EUR |
9.90 лв.
-
![The Osterman Weekend]()
печатна:
7.15 EUR |
14.00 лв.
-
![The Road to Gandolfo]()
печатна:
7.10 EUR |
13.90 лв.
-
![The Moscow Vector]()
печатна:
6.08 EUR |
11.90 лв.